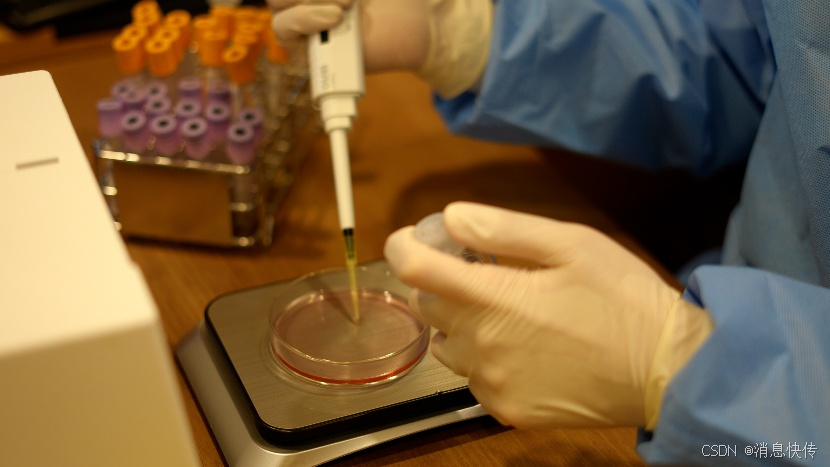

2025年2月21日,福特MustangGT3在全球最严苛的24小时汽车耐力赛之一——迪通拿劳力士24小时耐力赛中,以卓越的性能和团队协作,成功夺得GT3赛事的首场胜利。这一历史性的胜利不仅标志着福特MustangGT3在全球赛场上的崭露头角,也彰显了福特性能车团队及其合作伙伴MultimaticMotorsports的强大实力。
在迪通拿国际赛道上,福特MultimaticMotorsports车队的精英车手DennisOlsen、ChristopherMies和FrédéricVervisch驾驶着第65号MustangGT3赛车,在IMSAWeatherTechSportsCarChampionshipGTDPro组别的激烈角逐中,以出色的驾驶技术和赛车性能,成功抵挡住对手的多次冲击,最终赢得了这场里程碑式的胜利。与此同时,由SebPriaulx、MikeRockenfeller和AustinCindric组成的第64号MustangGT3赛车团队也表现出色,以第三名的成绩完赛,为福特原厂车队的胜绩锦上添花。
福特性能车团队全球总监MarkRushbrook在赛后表示:“这是集体力量的胜利,荣誉归于福特汽车公司、我们的合作伙伴以及每一位Mustang车迷。MustangGT3全球首冠,叠加福特在迪通拿劳力士24小时耐力赛第20次捧杯,意义深远。我们为付出的一切感到自豪,每个人都不负使命。”
自1967年Mustang品牌首次在迪通拿24小时耐力赛中夺冠以来,Mustang已经在这片赛场上取得了10次胜利。此次胜利不仅是MustangGT3的首场胜利,也是福特汽车公司自1966年MKII赛车赢得首胜以来的第20次登顶迪通拿24小时耐力赛的最高领奖台。上一次福特在该赛事中夺冠是在2018年,当时福特GT在GTLM组别中拔得头筹。
在比赛中,MustangGT3赛车展现出了卓越的性能和稳定性。车手们凭借精湛的驾驶技术和对赛车的深刻理解,成功应对了赛道上的各种挑战。特别是在比赛的最后几小时,第65号赛车团队在多次受到对手冲击的情况下,依然能够保持领先,并最终将胜利收入囊中。
此次胜利不仅是对福特MustangGT3赛车性能的肯定,也是对福特性能车团队和MultimaticMotorsports团队协作能力的认可。他们通过长期的努力和不懈的追求,终于在全球最高水平的赛场上取得了突破性的成绩。

展望未来,福特MustangGT3将继续在各大赛场上展现其卓越的性能和实力。福特性能车团队也将继续致力于推动赛车技术的发展和创新,为车迷们带来更多精彩的比赛和难忘的瞬间。同时,福特汽车公司也将继续秉承“创建一个更美好世界,让每个人都能自由出行、追逐梦想”的品牌愿景,为全球消费者提供更加优质的汽车产品和服务。
























 被折叠的 条评论
为什么被折叠?
被折叠的 条评论
为什么被折叠?








